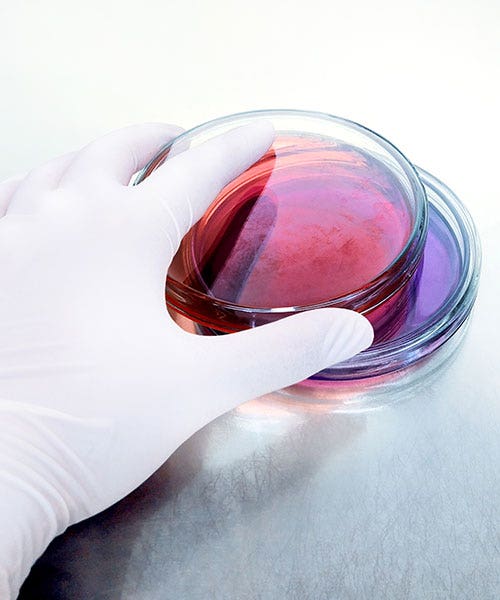
Driving efficiency

Digital & AI-Powered Solutions
Unifying Insight, Speed, and Precision across the Therapeutic Lifecycle
We see a way to
Our principles

We partner deep
The right team will help you achieve measurably improved outcomes in utilization, cost, capacity, risk, and time. By offering you one point of contact, we source the right expertise from Danaher Life Sciences’ entire ecosystem of engineering, science, and technology innovators.Talk to an Expert -->

Integrated workflows
Critical to your team and unique to Danaher are Solution Architects, who look at your entire bioprocess—not just fragments of it— to eliminate bottlenecks, pain points, and redundant steps along your R&D pathway. How? We innovatively integrate, automate, and digitalize your complex workflows— end to end—to deliver quantifiable value across your labs.See Our Workflows -->
Driving efficiency
The Danaher Business System powers our constant cycle of change and improvement. This unique approach allows our exceptional people to develop innovative recommendations, then realize them using world-class solutions and products to construct sustainable processes, resulting in superior outcomes.See Our Process -->
Browse, consult, and stay ahead with our expert-curated insights.
SCIEX
Intabio ZT System
Comprehensive charge variant analysis made simple
The Intabio ZT system couples icIEF separation and UV detection with high resolution mass spectrometry on the ZenoTOF 7600 system.


Danaher Corporation
abcam
Helping to accelerate the next breakthrough in drug discovery, diagnostics and basic research.

Danaher Corporation
Aldevron
Aldevron is a biologics CDMO powering genomic medicine pioneers from discovery to launch through expertise, innovations and operational excellence.

Danaher Corporation
Beckman Coulter Life Sciences
For more than 80 years, Beckman Coulter has been a trusted partner for laboratory professionals, helping to advance scientific research and patient care.

Danaher Corporation
Genedata
Genedata provides enterprise software solutions that digitalize and automate data-rich and complex biopharma R&D processes.

Danaher Corporation
IDBS
IDBS provides purpose-built software solutions to address the data management challenges prominent across the BioPharma lifecycle and supply chain.

Danaher Corporation
IDT
IDT empowers researchers with the genomic solutions they need to turn discoveries into breakthroughs in disease and drug development research.

Danaher Corporation
Leica Microsystems
Leica Microsystems develops leading-edge microscopes and scientific instruments to power technological advances and touch lives in meaningful ways.

Danaher Corporation
Molecular Devices
Molecular Devices provides high-performance bioanalytical measurement solutions for life science research, pharmaceutical and biotherapeutic development.

Danaher Corporation
Phenomenex
Phenomenex is a global technology leader committed to developing novel analytical chemistry solutions that solve the separation and purification challenges.

Danaher Corporation
SCIEX
At SCIEX, our mission is to deliver solutions for the precision detection and quantification of molecules, empowering our customers to protect and advance the wellness and safety of all.

